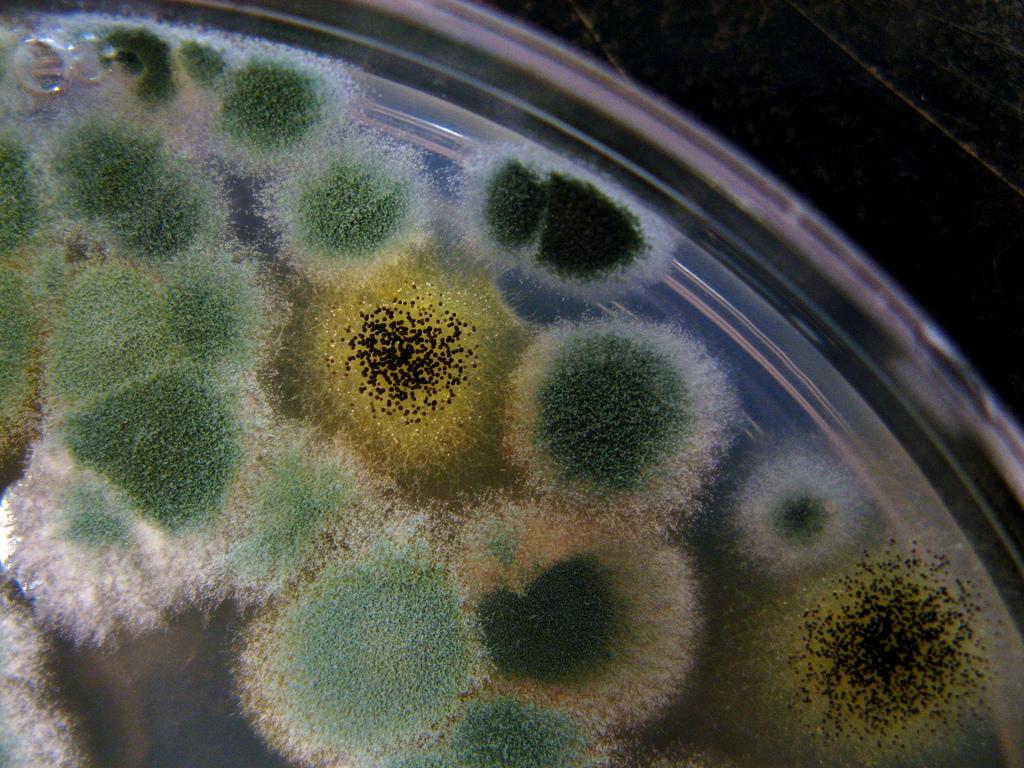

Polymikrobiální biofilmy v lůžku rány narušují vysoce koordinované a na sebe navazující procesy hojení rány. Studie zabývající se biofilmem chronických ran byly dosud zaměřeny téměř výhradně na bakterie.
Výzkumníci v Pensylvánii a Iowě se ve své nové studii zaměřili na společenství plísní a kvasinek, která spolu s bakteriemi vytváří smíšené biofilmy. Jejich studie zveřejněná v on-line časopise mBio zahrnuje důkladnou charakterizaci plísní a kvasinek, které se mohou nacházet u diabetických vředů, a studuje jejich podíl na vzniku nehojících se ran a jejich komplikací.
80 procent ran obsahovalo plísně a kvasinky
Výzkumný tým sledoval 100 pacientů s diabetickými vředy v průběhu 26 týdnů, nebo dokud rány nebyly zhojeny či stav pacienta nevyžadoval amputaci. Jednou za dva týdny byl pacientům odebrán vzorek tekutiny z rány a vyšetřen na přítomnost plísní a kvasinek.
Vědci se snažili zjistit, které druhy plísní a kvasinek tvoří společenství, kterým se daří hluboko uvnitř chronické rány a jakou roli by mohly sehrát u nehojících se ran. 80 % ran obsahovalo plísně a kvasinky, a to celkem 284 různých druhů. Nejhojněji bylo zastoupeno Cladosporium herbarum nalezené u 41 % vzorků a druhým nejčastějším patogenem byla kvasinka Candida albicans objevující se přibližně u jedné pětiny vzorků.
Plísně a kvasinky izolované z ran tvořily smíšený biofilm
Nebyla prokázána souvislost mezi zhoršeným hojením rány a některým konkrétním druhem plísně nebo kvasinky. S pomalým hojením nebo komplikacemi, jako je kostní infekce nebo amputace, byla spojena spíše smíšená společenství. Avšak u ran, jejichž hojení trvalo déle než 8 týdnů, bylo na počátku studie zjištěno vyšší zastoupení plísní ze skupiny askomycetů.
Cílem důkladnějšího zkoumání ran dvou pacientů bylo zjistit, zda by jejich stabilní společenství mikrobů mohla vytvářet biofilmy, které pravděpodobně způsobují hnisající rány. U pacienta, jehož rána se nakonec zahojila, byly izolovány kvasinky C. albicans a bakterie Citrobacter freundii a u pacienta, který musel podstoupit amputaci, pak kvasinka Trichosporon asahii a bakterie Staphylococcus simulans. Když byly tyto páry organismů společně kultivovány v laboratoři, zjistilo se, že vytváří smíšený biofilm.
Kvasinky a plísně významně ovlivňují hojení
Výsledky studie naznačují, že plísně a kvasinky jako složka biofilmu mohou významným způsobem přispívat ke zhoršenému hojení chronických ran. Zdá se, že polymikrobiální interakce v ráně, tedy vzájemné působení bakterií, plísní a kvasinek, hrají důležitou roli při hojení ran a významně ovlivňují imunitní systém.
Uvedená studie představuje významný krok směrem k lepšímu pochopení chronických ran a vývoji nových a efektivnějších metod jejich léčby.